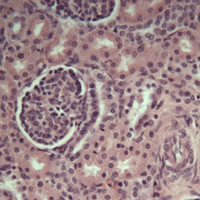

Advanced Microscopy Facility
The Advanced Microscopy Facility (AMF) provides resources, equipment and services for:
- Sample Preparation for Light Microscopy, Transmission and Scanning Electron Microscopy, and Histology
- Light Microscopy: Bright-Field, DIC, Fluorescence, Confocal
- Paraffin Histology for Light Microscopy
- Plastic Sectioning for Light Microscopy
- Ultra-thin Plastic Sectioning for Transmission Electron Microscopy
- Electron Microscopy (SEM, TEM)
- Individualized training in microscopy techniques and equipment use
Imaging Equipment Available is below.
For enquiries and booking email bioamf@ualberta.ca
- Olympus FLUOVIEW FV3000 Confocal Laser Scanning Microscope
- Leica DMRXA Compound Light Microscope with QI Click Camera
Bright field and Fluorescent Imaging; X 1.6, 10, 20, 40, 100 lenses
- Olympus SZ61 TR Stereo Light Microscope with SeBaCam 5.1MP Camera
Olympus Stereo Light Microscope, Top and bottom Illumination
- ZEISS AXIO A1 Compound Light Microscope with SeBaCam 5.1MP Camera
X 2, 5, 10, 20, 40, 63
- ZEISS Axio Imager M2
The ZEISS Axio Imager M2 is for brightfield and multi-channel fluorescence imaging and is equipped with two cameras, colour (Axiocam 105 Colour Camera) and monochrome (Axiocam 506 Monochrome Camera).
The M2 has a motorized stage and is capable of acquiring Z-stack images.
- ZEISS EVO 10 Scanning Electron Microscope (SEM)
High-resolution secondary electron imaging.
- Philips / FEI (Morgagni) Transmission Electron Microscope with Gatan Camera
Image acquisition is by Gatan CCD camera. Image analysis and enhancement are available. Maximum magnification for most samples is 110,000X.
Resources, equipment and services are available to the University of Alberta and external clients.
Please see our general policies, safety policy, user fees, and imaging equipment list for more information about MF services.
General Policies
Data: The AMF is not responsible for data generated by clients. Data storage and safekeeping is the responsibility of the end user. Data older than six months will be deleted from MF computers.
Training: Clients may not use equipment until they have been properly trained.
Cancellations: To cancel or modify your equipment bookings, contact Kacie Norton (bioamf@ualberta.ca). No charge will be applied for bookings cancelled at least 24 hours in advance or due to circumstances beyond the user's control. Failure to show up without explanation may result in being charged for the entire booked time slot.
Safety: Please familiarize yourself with the microscopy safety policy below. Failure to follow safety protocols may result in losing access to the MF.
Safety Policy
Clients are strongly advised to read and understand University of Alberta EHS policies and emergency procedures.
Client PPE Checklist: Please print the PPE Checklist (PDF, 162kb), sign, and return it to the AMF before starting projects
User Fees
These fees are per hour.
|
|
Biological Sciences |
Univ. of Alberta |
External |
|
TEM |
$50/hr |
$60/hr |
$100/hr |
|
SEM** |
$40/hr |
$50/hr |
$100/hr |
| Confocal FV3000** | $30/hr | $30/hr | $100/hr |
** an additional $50/hr is charged for training and/or assistance
A speedcode is the preferred method of payment but an invoice may be issued for an additional administration fee.
There is no charge for use of the stand-alone computer workstations with Photoshop or ImageJ. The usage of consumables and services is recorded in various log books for billing purposes.
There is a set fee for other services such as sample processing and sectioning, etc. The details of these costs are available upon request. Unique projects may require cost calculations and projections. For these special applications please contact Kacie Norton (bioamf@ualberta.ca) for a quote.
Sponsors
Imaging Links
![]() |
![]() |
![]() |
![]() |
![]() |
![]() |
![]() |
![]() |
![]() |